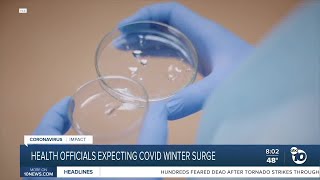

Watching the new COVID 19 variants as winter approaches video
Online izle ve mp4 mp3 formatlarinda yukle

Videonun muddeti: 2:57
Watching the new COVID 19 variants as winter approaches videosu mp4 ve mp3 yuklemek ucun hazirdir
Diqqet! Siz Mp4 yukle ve ya Mp3 yukle duymesine basdiqdan sonra eger sistem sizi reklam sehifesine atarsa o zaman derhal geri qayidib emeliyyati tekrar edin ve faylin yuklemek ucun hazir olmasini gozleyin
Videodan Mp4 Yukle
Videodan Mp3 Yukle-1
Videodan Mp3 Yukle-2
Oxshar Axtarishlar
 Watching the new COVID-19 variants as winter approaches
Watching the new COVID-19 variants as winter approaches Health Experts Warn Of New Omicron Subvariants As Winter Approaches
Health Experts Warn Of New Omicron Subvariants As Winter Approaches New COVID 19 Variants: What Can We Expect This Fall and Winter - Franciscan Health Podcast
New COVID 19 Variants: What Can We Expect This Fall and Winter - Franciscan Health Podcast New COVID-19 variant fueling winter surge
New COVID-19 variant fueling winter surge Can We Outsmart New COVID-19 Variants? | The Agenda
Can We Outsmart New COVID-19 Variants? | The Agenda What do variants change about the approach to COVID-19?
What do variants change about the approach to COVID-19? Fauci says new COVID-19 variants "are of concern"
Fauci says new COVID-19 variants "are of concern" COVID-19 Update | New variants are poised to drive a winter Covid-19 surge
COVID-19 Update | New variants are poised to drive a winter Covid-19 surge Health officials expecting Covid winter surge
Health officials expecting Covid winter surge
Video Mp4 Mp3Azwap.Biz
Azwap.Biz 2021-2023


 Watching the new COVID-19 variants as winter approaches
Watching the new COVID-19 variants as winter approaches Health Experts Warn Of New Omicron Subvariants As Winter Approaches
Health Experts Warn Of New Omicron Subvariants As Winter Approaches New COVID 19 Variants: What Can We Expect This Fall and Winter - Franciscan Health Podcast
New COVID 19 Variants: What Can We Expect This Fall and Winter - Franciscan Health Podcast New COVID-19 variant fueling winter surge
New COVID-19 variant fueling winter surge Can We Outsmart New COVID-19 Variants? | The Agenda
Can We Outsmart New COVID-19 Variants? | The Agenda What do variants change about the approach to COVID-19?
What do variants change about the approach to COVID-19? Fauci says new COVID-19 variants "are of concern"
Fauci says new COVID-19 variants "are of concern" COVID-19 Update | New variants are poised to drive a winter Covid-19 surge
COVID-19 Update | New variants are poised to drive a winter Covid-19 surge Health officials expecting Covid winter surge
Health officials expecting Covid winter surge